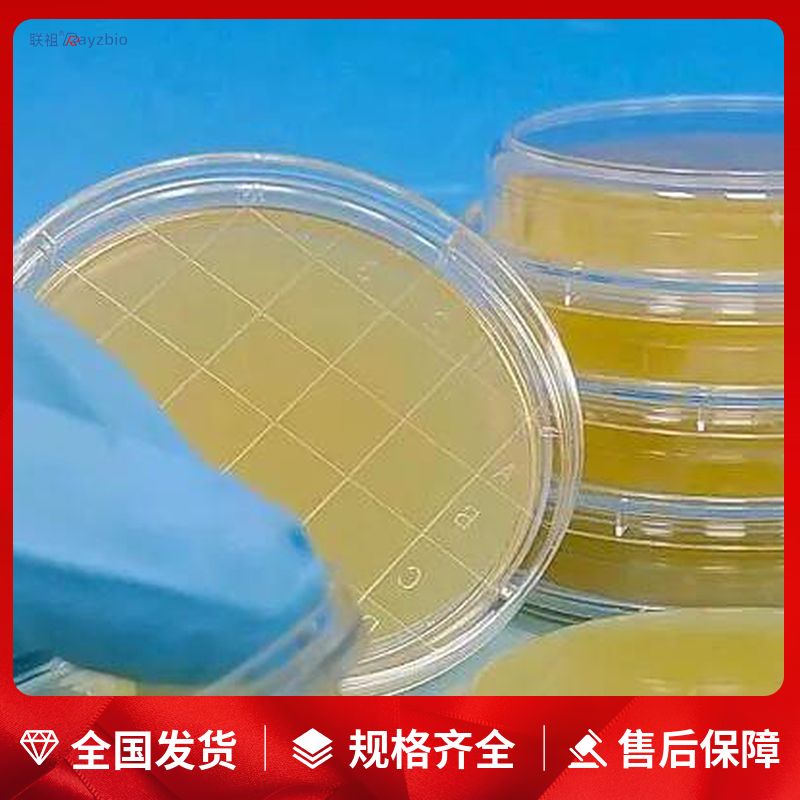
产品封面图

相关产品推荐更多 >
万千商家帮你免费找货
0 人在求购买到急需产品
- 详细信息
- 文献和实验
- 技术资料
- 库存:
42
- 英文名:
YM Medium
- 供应商:
上海联祖
- 规格:
V
英文名称:YM Medium
产品规格:250g
发货周期:1~3天
产品价格:询价
| 货号 | 规格 | 发货期 | 用途 |
| LZ-PYJ3999 | 250g | 1~3天 | 仅供科研实验 |
用法:称取本品21.0g,加热溶解于1000ml蒸馏水中,121℃高压灭菌15分钟,备用。
培养基的计数方法:
一、稀释涂布平板法(亦称活菌计数法)是一种常用的微生物计数方法,其原理是当样品的稀释度足够高时,培养基表面生长的一个菌落来源于样品稀释液中的一个活菌。通过统计平板上的菌落数,可以推测出样品中大约含有多少活菌。这种方法操作简便,适用于菌体大小和质量都相近的类群,如细菌、酵母菌等的计数。计算公式为每克样品中的菌株数=C/V*M,其中C代表某一稀释度下平板上生长的平均菌落数,V代表涂布平板时所用的稀释液的体积(mL),M代表稀释倍数。
二、显微镜直接计数法利用特定细菌计数板或血细胞计数板,在显微镜下计算一定容积的样品中微生物数量。这种方法不能区分死菌与活菌,但可以估算出1mL培养中液中细胞个数,计算公式为1mL 培养中液中细胞个数=小方格中细胞平均数×400 ×104×稀释倍数(个/mL)。显微镜直接计数法的缺点是不能区分死菌与活菌,因此计数到的细胞数包括了死亡的细胞数。
公司正在出售的产品:
细胞CDK5/P25激酶活性定量检测试剂盒(A/B/C)
组织CDK5/P25激酶活性定量检测试剂盒(A/B/C)
细胞CDK5/P35激酶活性定量检测试剂盒(A/B/C)
组织CDK5/P35激酶活性定量检测试剂盒(A/B/C)
细胞CDK6/CYC D1激酶活性定量检测试剂盒(A/B/C)
Chicken Transforming Growth factor β3 ELISA Kit,Transforming Growth factor β3,TGF-β3
Chicken Vitellogenin ELISA Kit,Vitellogenin,VTG
Chicken infectious coryza Antibody ELISA Kit,infectious coryza Antibody,IC Ab
Chicken Noradrenaline ELISA Kit,Noradrenaline,NE
Chicken Vascular Endothelial cell Growth Factor A ELISA Kit,Vascular Endothelial cell Growth Factor A,VEGF-A
细胞半胱-3(CASPASE-3)活性比色法定量检测试剂盒
组织半胱-2(CASPASE-2)活性荧光定量检测试剂盒
细胞半胱-2(CASPASE-2)活性荧光定量检测试剂盒
组织半胱-2(CASPASE-2)活性比色法定量检测试剂盒
ECF ELISA Kit ESX1 Antibody Blocking Peptide
MIP-1α/CCL3 ELISA Kit LFABP Antibody Blocking Peptide
ICAM-2/CD102 ELISA Kit C7orf63 Antibody Blocking Peptide
BGP/Gehrelin ELISA Kit CCR2 Antibody Blocking Peptide
FⅫ ELISA Kit GGN Blocking Peptide
HSP-90 ELISA Kit SMARCA4 Antibody Blocking Peptide
LMWH ELISA Kit phospho-Akt (Thr450) Antibody Blocking Peptide
GH ELISA Kit Recombinant human MPO protein
VD ELISA Kit MKX Antibody Blocking Peptide
JE ELISA Kit Claudin 1 Antibody Blocking Peptide
ATA ELISA Kit AKT2 Antibody Blocking Peptide
TF ELISA Kit RASAL3 Antibody Blocking Peptide
β-hexosaminidase ELISA Kit GMPR1 Antibody Blocking Peptide
PGM ELISA Kit phospho-EIF2S1 (Ser49) Antibody Blocking Peptide
Glyceryl Trioleate
Dictamnine
BrevilinA
Isoferulic Acid
YM培养基1/2改良型霍格兰营养液(干粉+浓缩液) 1/2 Hoagland modified nutrient salts 500L
1/4改良型霍格兰营养液(干粉+浓缩液) 1/4 Hoagland modified nutrient salts 1000L
缺锌Yoshida水稻营养液(干粉) Yoshida rice nutrient salts(-Zn) 4×250g
培养基操作步骤:
一、用法:称取本品33.0g,加热溶解于1000ml蒸馏水中,分装三角瓶,121℃高压灭菌15分钟,备用。
二、配料:首先,根据培养基的配方,准确称量各种成分,包括粉状和非粉状的成分,如肉膏等,放入烧杯中。
三、溶化:向烧杯中加入适量的水,然后搅拌以溶解各成分。对于含有琼脂的培养基,应注意防止外溢,并在溶化过程中保持搅拌。
四、矫正pH:在培养基溶解均匀并冷却至室温后,使用pH试纸测量pH值,然后根据需要加入酸或碱来调整至合适的pH值。
五、澄清过滤:使用滤纸或多层纱布对培养基进行过滤,以去除杂质。
六、分装:将制备好的培养基分装入试管内或三角瓶内,确保管(瓶)口塞上棉塞,以防止外界微生物污染。
七、灭菌:对分装好的培养基进行灭菌处理,通常是通过高压灭菌来确保无菌环境。
八、检定:灭菌后的培养基可以进行质量检定,以确保其符合使用要求。
风险提示:丁香通仅作为第三方平台,为商家信息发布提供平台空间。用户咨询产品时请注意保护个人信息及财产安全,合理判断,谨慎选购商品,商家和用户对交易行为负责。对于医疗器械类产品,请先查证核实企业经营资质和医疗器械产品注册证情况。
文献和实验相关专题 微生物 基础培养基是人工配制的用于培养微生物的一个混合营养制品,基础培养基中含有维持微生物正常生长的营养物质,此培养基的PH值一般为7.2-7.6。某些特殊的微生物需要的PH可能偏酸或偏碱性。 培养基是根据微生物 生长繁殖时对营养物质的需要而配制的营养制品,含有营养物质及适宜的酸碱度,经灭菌后使用。 常用的培养基按用途分为:基础培养基、营养培养基、鉴别培养基、选择培养基及厌氧培养基。按物理
树突状细胞培养操作步骤 准备补充剂 将补充剂混合物在 15~25℃ 解冻。在无菌条件下用移液枪小心地将补充剂混合物混匀。然后,把补充剂混合物全部加到基础培养基中。盖上瓶子,轻轻混匀直到形成均一的混合物。DC生成培养基所附带的相应的细胞因子组合包含有成分A和B,它们都是以100X 的原液状态运输的。 注意:此时不要将化合物B加入培养基中。 DC基础培养基不带细胞因子,因此使用时必须另外自行添加。 新鲜分离的单核 DC 细胞的传代 对于新鲜分离自外
培养基历史 体外培养( in vitro culture )包括:组织培养( tissue culture )、细胞培养( cell culture )、器官培养( organ culture )。顾名思义,就是将活体结构成分(如活体组织、活体细胞或者活体器官等)从体内或其寄生体内取出,放在类似于体内生存环境的体外环境中,让其生长发育的方法。广义组织培养与体外培养同义。体外培养已经历了约一百年的发展历史,但发展初期进程比较缓慢,没有引起很多学者的重视。直到上世纪 50 年代后期,体外
技术资料暂无技术资料 索取技术资料